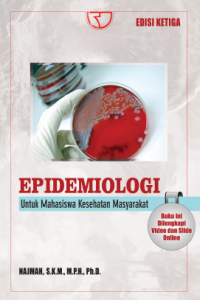

Text
Epidemiologi: Untuk Mahasiswa Kesehatan Masyarakat
Tidak Tersedia Deskripsi
Ketersediaan
Tidak ada salinan data
Informasi Detail
Judul Seri |
-
|
---|---|
No. Panggil |
-
|
Penerbit | Rajawali Pers : Depok., 2019 |
Deskripsi Fisik |
xxviii, 246 hlm., 23 cm
|
Bahasa |
|
ISBN/ISSN |
978-602-425-052-2
|
Klasifikasi |
NONE
|
Tipe Isi |
-
|
Tipe Media |
-
|
Tipe Pembawa |
-
|
Edisi |
2 Cet 3
|
Subjek | |
Info Detail Spesifik |
-
|
Pernyataan Tanggungjawab |
-
|
Versi lain/terkait
Tidak tersedia versi lain